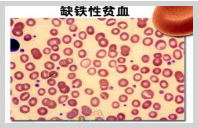

喝饮料也会面黄肌瘦骨质疏松
2017-08-09 17:30:41 发表 阅读 (99)饮食包含两个方面,一个是吃,通过食物来满足人体营养需求;一个是喝,通过水来满足人体体液代谢需求。这两个方面都非常重要,不过今天要说的是喝的问题...[阅读全文]
儿童之家打通儿童福利服务“最后一公里”
2017-08-09 17:25:16 发表 阅读 (96)据最新消息,河南出台了《关于推进基层儿童福利服务体系建设工作的通知》,打通儿童福利服务“最后一公里”。...[阅读全文]
夏季保护宝宝皮肤不受损伤法宝
2017-07-27 09:26:37 发表 阅读 (145)夏季是皮肤病的高发时节,这不仅与日照、冷空气、潮湿有关,也与人的免疫力有关。宝宝皮肤娇嫩,免疫力又比较弱,因此是高危对象。...[阅读全文]
夏季保护宝宝皮肤不受损伤法宝
2017-07-27 09:26:37 发表 阅读 (145)夏季是皮肤病的高发时节,这不仅与日照、冷空气、潮湿有关,也与人的免疫力有关。宝宝皮肤娇嫩,免疫力又比较弱,因此是高危对象。...[阅读全文]
如何提高小儿脾胃功能强壮身体
2017-07-26 16:49:08 发表 阅读 (193)人体健康强壮的先天之本是肾,后天之本是脾胃。肾大家都不陌生,胃也都知道,但是对于脾可能很多人比较陌生。但实际上脾与胃是黄金搭档...[阅读全文]
孩子生病哪些药可以自己做主用哪些不行
2017-07-24 16:10:26 发表 阅读 (113)不少儿科医生都有这样的感慨:很多父母根本不知道该怎么给孩子用药。有的发着39度的高烧来就诊,家长说怕吃了退烧药耽误诊断;有的咳嗽了好几天,家长没空带孩子去医院...[阅读全文]
.jpg)

.gif)

